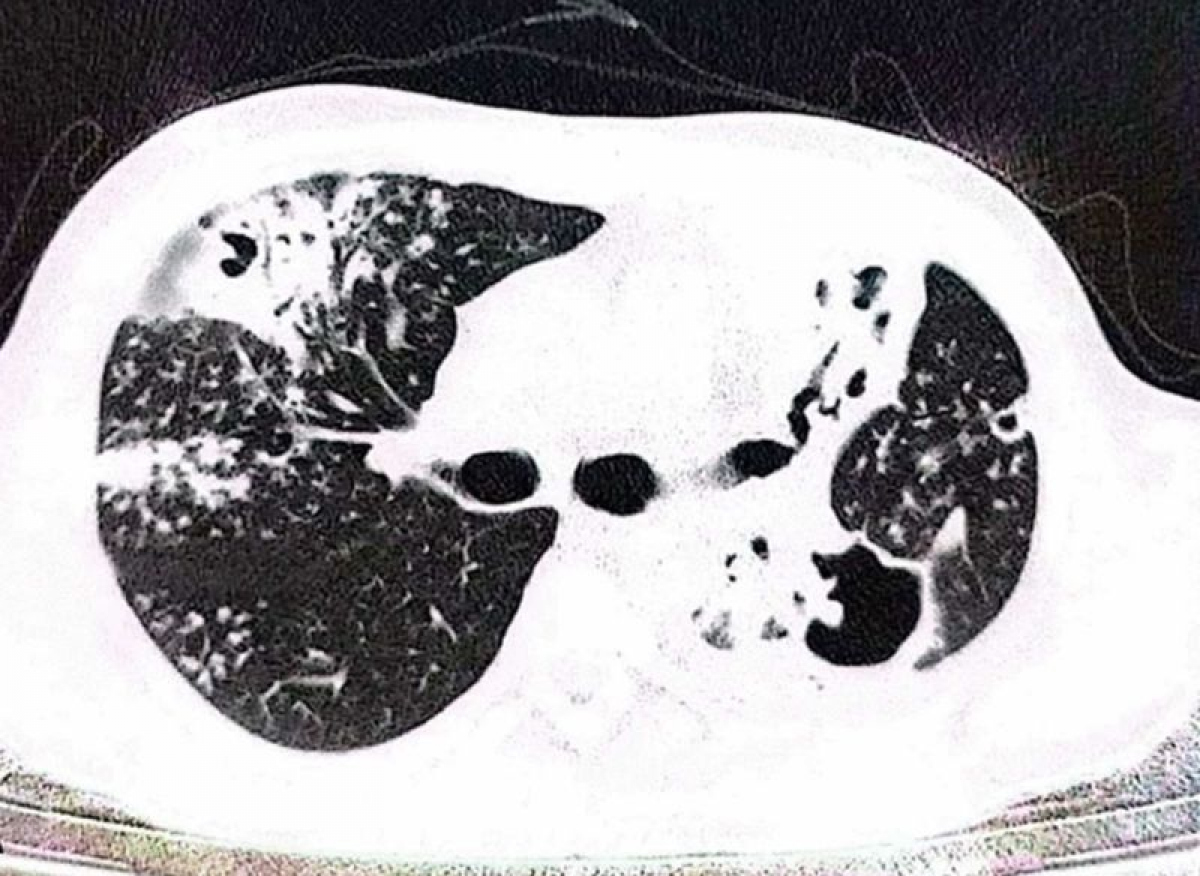

Houbu objevenou v plících pacienta pojmenovali po českém vědci
Mezinárodní tým mykologů z Nizozemí a Iránu objevil u íránského pacienta s dýchacími problémy nový druh houby způsobující plicní onemocnění. Pojmenovali ji Aspergillus hubkae jako výraz ocenění za dlouhodobou práci českého vědce Víta Hubky (38 let) z Mikrobiologického ústavu AV ČR. V historii české vědy bylo takto mladému výzkumníkovi uděleno podobné uznání velmi výjimečně.
Vít Hubka se s týmem kolegů z Akademie věd ČR a Univerzity Karlovy za posledních 12 let podílel na objevu téměř 100 nových druhů hub, z toho 60 druhů rodu Aspergillus, česky kropidlák.
Nedávno objevený druh Aspergillus hubkae patří do skupiny tzv. černých aspergilů, které se běžně vyskytují v půdě, ovzduší i na potravinách. Využívají se například k výrobě kyseliny citronové nebo k fermentaci potravin a nápojů, včetně populárního čínského čaje Pu-erh.


Některé druhy však kontaminují nebo znehodnocují ovoce, zeleninu a potraviny. Jejich nežádoucí přítomnost se bedlivě sleduje, protože houba produkuje karcinogenní toxiny, které mohou lidem i zvířatům způsobovat závažné zdravotní problémy v podobě infekcí.
Mezi nejčastější patří zánět zvukovodu, zánět oční rohovky nebo invazivní aspergilóza. U zdravého člověka se poslední jmenované závažné onemocnění, nejčastěji postihující plíce, nerozvine, neboť imunitní buňky vdechnuté spory odstraní. U člověka s oslabenou imunitou ale mohou spory klíčit a růst v plicní tkáni, která se stane pro houbu zdrojem živin.
O výskytu nového druhu houby Aspergillus hubkae je zatím známo velmi málo. Není jasné, jak rozšířený tento druh je a jak časté mohou být infekce jím způsobené.
Rozdílná reakce na léky
Jediný nález pochází od pacienta z Íránu, u kterého v roce 2022 způsobil invazivní plicní aspergilózu. Konkrétní pacient byl léčen pro tuberkulózu a jeho organismus byl také zatížen závislostí na opiu.

„K podezření, že se jedná o nový druh houby, došlo primárně podle sekvenace DNA vzorku houby izolované z iránského pacienta a po studiu genetických příbuzností s již známými druhy. Posléze bylo zjištěno, že příbuzné druhy vykazují i další odlišnosti. Například rozdíly v rychlosti růstu, zabarvení kolonií nebo velikosti a povrchové struktuře spor,” vysvětluje mikrobiolog a mykolog Vít Hubka.
„Nejvíce příbuzný druh, A. brasiliensis, který byl také několikrát zachycen jako patogen, vykazuje i odlišné citlivosti k antimykotikům. Aspergillus hubkae je totiž rezistentní k léčivu itrakonazol, kdežto A. brasiliensis je citlivý. Protože je ale nový druh zatím známý jen z jednoho klinického případu, je nutné všechny atributy v budoucnu ověřit u většího počtu izolátů. Není totiž jasné, jak velká může být vnitrodruhová variabilita ve jmenovaných znacích,“ dodává Vít Hubka.
O pojmenování houby na počest Víta Hubky rozhodli mykologové z Nizozemí a Íránu, kteří nový druh společně objevili a popsali v nedávné publikaci. Usoudili, že dlouhodobý výzkum českého vědce, včetně jeho komplexní publikace o tzv. černých aspergilech z roku 2022, je natolik významný, že si to jednoznačně zaslouží.
„Velmi mě těší uznání komunity za práci, kterou jsem v oboru mykologie doposud vykonal. Ale také to beru do budoucna jako závazek snažit se o vysoký standard kvality výzkumu a jako morální závazek,” zdůrazňuje Vít Hubka.
Zdroj: Tisková zpráva Mikrobiologického ústavu AV ČR
Zdroj fotografií: Zhou et al. (2024) Mycopathologia 189: 44. https://doi.org/10.1007/s11046-024-00848-z












